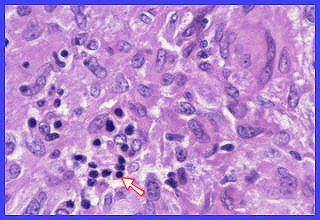

Although non-necrotizing granulomas are the usual finding in sarcoidosis, necrosis does occur. Prior to the widespread use of transbronchial biopsy necrosis was reported in up to 30% of large biopsy specimens (open lung, lymph node). The incidence of necrosis is far lower in small specimens such as transbronchial biopsies because of the small number of granulomas usually sampled. Compared with the necrosis seen in infectious granulomas the necrosis in the granulomas of sarcoidosis is most often focal, very small in size and involves very few of the granulomas. The foci of necrosis are acidophilic with a fibrinoid, granular appearance and usually located within the centers of granulomas (Figs. 1,2). Rarely, biopsy material from patients with well-documented sarcoidosis will exhibit extensive necrosis resembling that seen in infectious and other granulomatous processes (Figs. 4,5). Suppurative necrosis may also occur but is very rare in sarcoidosis (Fig. 6)

Programmed cell death, known as apoptosis, has been postulated to play a major role in granuloma regression. Apoptotic cells, often referred to as apoptotic bodies, have been identified in the granulomas of sarcoidosis, tuberculosis, leprosy, Crohn's disease and in foreign body granulomas (Cree IA et al. J Clin Pathol 1987;40:1314-19). Apoptotic bodies are ovoid or spherical and exhibit nuclear chromatin condensation and/or fragmentation, cytoplasmic eosinophilia, and separation from surrounding cells and from each other. It is likely that apoptotic bodies within granulomas are formed from both epithelioid cells and lymphocytes. In my experience with sarcoidosis apoptotic bodies are most often seen in close association with small foci of necrosis (Figs. 7-11). They may also be seen in the absence of necrosis (Figs. 12-14).
Apoptosis and Apoptotic Bodies
Fig. 1 Sarcoidosis: small focus of necrosis. The most common appearance of necrosis in sarcoidosis
Fig. 2 Sarcoidosis: small focus of necrosis. The most common appearance of necrosis in sarcoidosis
Fig. 3 Sarcoidosis: larger focus of necrosis. An unusually large amount of necrosis for sarcoidosis.
Fig. 4 Sarcoidosis: Lymph node with extensive necrosis. This degree of necrosis is very rare in sarcoidosis
Fig. 5 Sarcoidosis: Lymph node with large foci of confluent necrosis. This degree of necrosis is very rare in sarcoidosis.
Fig. 7 Sarcoidosis: Apoptotic bodies with small focus of necrosis between arrows.
Fig. 8 Sarcoidosis: Apoptotic bodies with small focus of necrosis to right of arrowhead.
Fig. 9 Sarcoidosis: Apoptotic bodies with small focus of necrosis between arrows.
Fig. 10 Higher magnification of Fig. 8. Note fragmentation of apoptotic bodies.
Fig. 11 Sarcoidosis: Apoptotic bodies with small foci of necrosis at arrowheads.
Fig. 12 Sarcoidosis: Apoptotic bodies without necrosis.
Fig. 13 Sarcoidosis: Apoptotic bodies without necrosis. Cytoplasmic eosinophiiia is evident.
Fig. 14 Sarcoidosis: Apoptotic bodies without necrosis. Cytoplasmic eosinophiiia is evident at the arrowhead.
Click on each image to view a larger image
Fig. 6 Sarcoidosis: A granuloma exhibiting suppurative necrosis, a very rare finding in sarcoidosis.
Click on each image to view a larger image